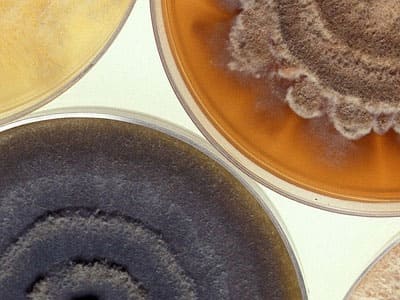

고콜레스테롤. 이상지질혈증. 고지혈증 등 혈중에 나쁜 콜레스테롤이 많아진 상태에서 콜레스테롤 수치를 낮춰주어 혈액을 깨끗하게 해 주는데 도움을 줄 수 있는 음식들. 오늘은 그 첫 번째로 홍국쌀에 대해 알아보겠습니다.
홍국쌀을 이루는 성분은 고지혈증 약인 로바스타틴과 동일한 성분입니다. 따라서, 홍국쌀의 부작용과 섭취를 금해야 하는 대상인지 반드시 확인하고 드셔야 합니다.
콜레스테롤 낮추는 음식 - 홍국

홍국쌀(붉은 효모 쌀 - Red Yeast Rice)이란?
홍국쌀은 누룩곰팡이(Monascus purpureus) 균으로 약 15~30일간 발효시킨 붉은 쌀입니다.
![]() |
![]() |
![]() |
높은 콜레스테롤 수치를 개선하는 최고의 자연식품 중 하나로, 발효되면서 생기는 붉은색의 모나콜린 K(monacolin-k)가 콜레스테롤을 분해하는 효능이 있는 것으로 알려져 있습니다. 이 모나콜린 K는 고지혈증 약으로 처방되는 로바스타틴과 동일한 성분입니다.
이미 예전부터 중국과 일본에서 생산된 홍국은 중국의 본초강목에서 1500년대 기술된 것으로 알려져 있습니다. 홍국 자체에 독성이 없으며, 혈액순환과 소화 기능을 좋게 하고 설사나 소화불량을 다스리는 것으로 기술되어 있는 역사가 깊은 식품입니다.
홍국 효능
홍국의 가장 큰 효능은 고콜레스레롤 수치 개선일 것입니다. 또한, 혈당 및 인슐린 수치 개선, 암세포 성장을 감소시키는데 도움을 주는 것으로 알려져 있습니다.
고콜레스테롤, 혈당 개선
스타틴과 동일한 홍국쌀의 모나콜린 K 성분은 나쁜 LDL 콜레스테롤의 수치를 낮춰주어 고콜레스테롤을 개선하는데 도움을 줍니다. 홍국쌀을 하루 1.2g을 복용했을 경우 8주에 나쁜 LDL 콜레스테롤 수치가 26% 낮아졌으며, 하루 2.4g씩 12주를 섭취한 사람의 경우 나쁜 LDL 콜레스테롤 수치가 22%, 총콜레스테롤이 16% 감소한 연구결과가 있습니다.
![]() |
![]() |
![]() |
고콜레스테롤은 심장병을 일으키는 위험 요소 중 하나이므로 콜레스테롤의 수치가 감소될 경우 심장 건강에 도움을 준다고 말할 수도 있겠습니다.
홍국쌀은 LDL 콜레스테롤뿐만 아니라 중성지방(트리글리세리드)의 수치 또한 낮추고 혈압을 감소시키는데 도움을 줍니다. 대사 증후군 환자가 홍국쌀 보충제를 약 18주간 복용한 연구결과에 따르면 혈당과 인슐린 수치, 고혈압 수치의 개선에 도움을 준 것으로 알려져 있습니다.
항암 효과, 염증 감소
![]() |
![]() |
![]() |
홍국쌀을 이용한 한 연구결과, 암세포의 성장을 막는 것으로 알려져 있습니다. 면역체계를 방해하는 몸속 염증을 줄여주어 당뇨병이나 심장병, 암과 같은 만성 질환의 위험에 빠지는 것을 감소시켜준다고 알려져 있습니다.
홍국 부작용
홍국을 섭취했을 때 흔한 부작용으로는 복부 팽만감이나 복통, 가스가 차는 등의 위장 문제가 있을 수 있습니다.
홍국의 모나콜린 K는 고지혈증 약인 로바스타틴의 부작용과 마찬가지로 근육통이나 그 외의 근육 관련 문제들과 간에 대한 문제가 생길 수 있기 때문에 미국 FDA에서는 건강기능식품으로 판매 금지를 1998년 명령한 바 있습니다. 하지만 우리나라에서는 별다른 제재 없이 판매가 진행되고 있고, 실제 쌀로 구매하여 밥을 지어먹기도 하는데요.
![]() |
![]() |
로바스타틴의 경우 임산부, 수유부가 섭취 시 기형이나 유산의 위험이 있기 때문에 로바스타틴과 동일한 성분이 들어있는 홍국쌀을 먹는 것은 반드시 금기하여야 합니다. 또한 약물과 상호작용으로 인해 부작용이 클 수 있으므로 다음과 같은 사람은 홍국쌀을 복용하지 말아야 합니다.
- 간 질환, 신장 질환이 있는 경우
- 임산부, 모유 수유부
- 이미 스타틴 계열의 약을 복용하고 있는 사람
(로바스타틴, 수바스 타틴, 플루 바스 타틴, 아토르바스타틴, 프라바스타틴, 심바스타틴 등) - 젬피 브로질 gemfibrozil ( Lopid) , 페노피브레이트 fenofibrate (TriCor)와 같은 콜레스테롤 약을 복용하는 사람
- 케토코나졸 (ketoconazole)-니조랄, 플루코나졸 (fluconazole), 이트라코나졸 (itraconazole) 같은 항진균제를 복용하는 사람
- 사이클로스포린(cyclosporin) 같은 면역억제 제약을 복용하는 사람
- 에리트로마이신(erythromycin), Clarithromycin (클래리트로마이신) - Biaxin 같은 항생제를 복용하는 사람
- 항우울제를 복용하는 사람
- 단백질 분해효소 억제제 (HIV 치료)를 복용하는 사람
- 효모, 곰팡이 알레르기가 있는 사람
그 외 갑상선 약이나 혈압약, 허브류 및 보충제와 상호작용할 수 있으니 섭취 전 반드시 의사와 상의 후에 섭취하셔야 합니다.
홍국쌀 하루 권장섭취량
![]() |
![]() |
홍국쌀은 로바스타틴과 동일한 성분으로 이루어져 있기 때문에 복용법과 섭취량을 반드시 알고 드셔야 합니다.
홍국쌀의 1.2~2.4g 정도에는 모나콜린 K가 약 5mg 들어있습니다. 로바스타틴을 5mg 먹는 것과 동일하다고 보시면 되는데요.
우리나라 식약처에서 건강기능식품 기능성 원료로 인정한 홍국쌀의 1일 섭취량은 총 모나콜리 K로서 4~8mg입니다.
홍국 보충제의 경우 하루 1,200mg~2,400mg를 2~3회 정도 나눠 섭취하는 것을 권장하고 있습니다.
하지만 홍국쌀의 적정한 복용량에 대해서는 반드시 의사와 상의 후에 결정하시고 섭취하시기 바랍니다.
홍국쌀 제품 고르는 법
![]() |
![]() |
홍국쌀이라고 나와있는 제품들이 전부 홍국쌀은 아닙니다. 콜레스테롤을 분해하는 물질인 모나콜린 K만 추출해서 일반 쌀에 코팅시키는 제품들은 실제 발효시킨 홍국쌀보다 모나콜린 케이의 함량이 1/10 정도밖에 되지 않아 효과가 떨어질 수 있습니다.
제대로 발효시킨 홍국쌀을 고르는 법은 쌀이 희끗한 부분 없이 골고루 전체가 진분홍색을 띠는지 확인하셔야 하며, 쌀을 반으로 쪼갰을 경우 안에까지 붉은빛을 띠는 것이 발효가 제대로 된 쌀이라고 할 수 있습니다.
홍국 보충제의 경우 홍국 함량이 얼마나 되는지를 확인하고 하루 섭취 권장량에 맞춰 구입하시는 것이 좋겠습니다.
- 2020/10/19 - [건강 정보] - 고지혈증과 당뇨, 커피 논란의 진실
- 2020/10/21 - [건강 정보] - 착한 비정제 탄수화물로 체지방 줄이는 법
- 고지혈증약 스타틴과 함께 먹으면 절대 안되는 금기음식